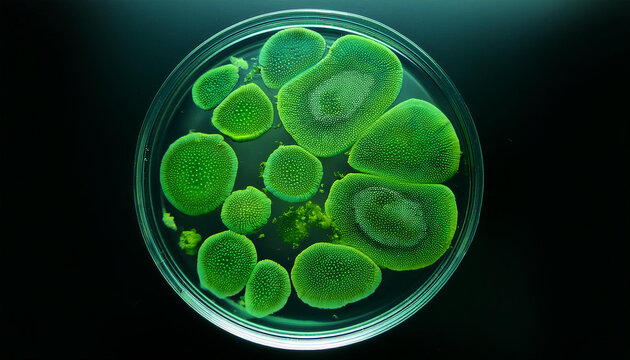
Microscopic view of green cells on round glass. Science, laboratory research. Macro shot. Top view.

- Home >
- Stock Photos >
- Macro View of Green Coronavirus Cells in Motion
Macro View of Green Coronavirus Cells in Motion Image

Image depicts detailed coronavirus particles in vibrant green on similar background. Perfect for medical and scientific presentations on virus transmission and public health campaigns, highlighting virus spread and pandemic awareness.
4
downloads
downloads
Tags:
More
Credit Photo
If you would like to credit the Photo, here are some ways you can do so
Text Link
photo Link
<span class="text-link">
<span>
<a target="_blank" href=https://pikwizard.com/photo/macro-view-of-green-coronavirus-cells-in-motion/60d6b188b79e77989c40c1755109c78a/>PikWizard</a>
</span>
</span>
<span class="image-link">
<span
style="margin: 0 0 20px 0; display: inline-block; vertical-align: middle; width: 100%;"
>
<a
target="_blank"
href="https://pikwizard.com/photo/macro-view-of-green-coronavirus-cells-in-motion/60d6b188b79e77989c40c1755109c78a/"
style="text-decoration: none; font-size: 10px; margin: 0;"
>
<img src="https://pikwizard.com/pw/medium/60d6b188b79e77989c40c1755109c78a.jpg" style="margin: 0; width: 100%;" alt="" />
<p style="font-size: 12px; margin: 0;">PikWizard</p>
</a>
</span>
</span>
Free (free of charge)
Free for personal and commercial use.
Author: Authentic Images